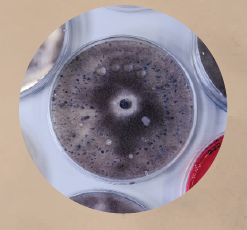

Nuevo estado de la materia
En la búsqueda de novedades dentro del mundo de las partículas ínfimas, el experimento CMS, que se lleva a cabo en el Gran Colisionador de Hadrones (LHC) del Centro Europeo de Investigaciones Nucleares (CERN), anunció en 2024 haber descubierto algo inusual, indicios de un evento peculiar luego de exhaustivo análisis de datos capturados entre 2016 y 2018. En julio de 2025 el experimento ATLAS dio otro paso a fin de corroborar la hipótesis acerca de la existencia de un estado fugaz de la materia luminosa, llamada toponium. Sabemos que hay en la naturaleza seis quarks, los constituyentes más pequeños de la materia visible. Todos, excepto el top quark, tienden a formar parejas o pequeños conglomerados que llamamos hadrones. Sin embargo, a lo largo de numerosas colisiones protón–protón en el LHC se confirmó la posibilidad de que dicho quark top, el más pesado y efímero, intercambie gluones en un abrir y cerrar de ojos cuántico con su par antimaterial, formando así una pareja, hasta ahora improbable, en un estado (resonancia lo llaman) que dura 2.3 x 10-25 segundos antes de disiparse.
Fuente: CERN

Las Horribles CERNettes
Al final del posmodernismo, antes de que un pequeño equipo comandado por Tim Berners–Lee y Robert Cailliau creara la World Wide Web basada en el primer internet, a principios de la década de 1990 un grupo de mujeres cercanas al CERN formaron un grupo retro que llegó a presentarse en el Festival Hadrónico de dicho centro de investigación, localizado en las afuera de la ciudad suiza de Ginebra. De hecho, en 1989 uno de estos científicos computacionales y organizador del festival, Silvano de Gennaro, escribió una canción bajo el título de Collider acerca de una chica sola y triste porque su galán trabaja largas jornadas… en el colisionador. Ante el éxito del grupo, grabaron un video en el anillo del acelerador y Silvano generó una imagen promocional, considerada la primera que se subió a la Web.
Fuente: BBC

Antibióticos diseñados mediante IA
El 13 de agosto de 2025 se dio a conocer que un grupo de investigadores del MIT (Instituto Tecnológico de Massachusetts) consiguió destruir las defensas de súper bacterias, resistentes a los antibióticos convencionales. Primero hicieron pasar por el tamiz de su algoritmo un amplio catálogo de sustancias químicas, potencialmente nocivas para tales súper bichos. Una vez seleccionadas las moléculas candidatas, eligieron dos idóneas que resultaron eficaces tanto en sus pruebas preliminares como en exámenes más avanzados con animales de laboratorio. Ahora dedicarán su esfuerzo, asistidos por IA, a fin de obtener nuevos antibióticos para combatir la transmisión de gonorrea y hacer frente a Staphylococcus aureus, resistente a la metacilina.
Fuente: BBC